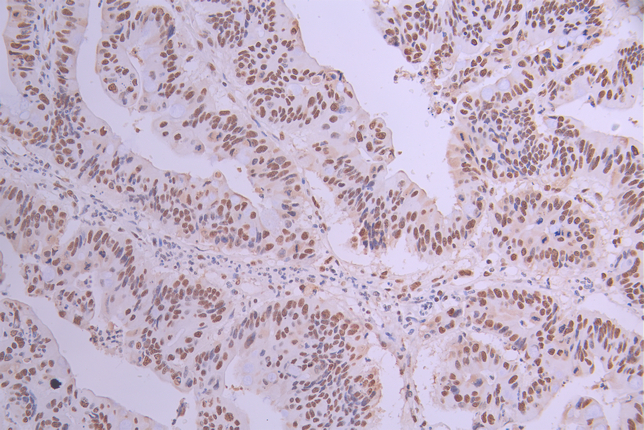

SET Recombinant Monoclonal Antibody
-
中文名稱:SET Recombinant Monoclonal Antibody
-
貨號(hào):CSB-RA561645A0HU
-
規(guī)格:¥1320
-
圖片:
-
Western Blot
Positive WB detected in: HeLa whole cell lysate(30μg), COLO205 whole cell lysate(30μg), HEK293 whole cell lysate, HL-60 whole cell lysate(30μg)
All lanes: SET antibody at 1:1000
Secondary
Goat polyclonal to rabbit IgG at 1/50000 dilution
Predicted band size: 33 kDa
Observed band size: 39 kDa
Exposure time: 2min -
IHC image of CSB-RA561645A0HU diluted at 1:100 and staining in paraffin-embedded human colorectal cancer performed on a Leica BondTM system. After dewaxing and hydration, antigen retrieval was mediated by high pressure in a citrate buffer (pH 6.0). Section was blocked with 10% normal goat serum 30min at RT. Then primary antibody (1% BSA) was incubated at 4°C overnight. The primary is detected by a Goat anti-rabbit polymer IgG labeled by HRP and visualized using 0.05% DAB.
-
IHC image of CSB-RA561645A0HU diluted at 1:100 and staining in paraffin-embedded human stomach tissue performed on a Leica BondTM system. After dewaxing and hydration, antigen retrieval was mediated by high pressure in a citrate buffer (pH 6.0). Section was blocked with 10% normal goat serum 30min at RT. Then primary antibody (1% BSA) was incubated at 4°C overnight. The primary is detected by a Goat anti-rabbit polymer IgG labeled by HRP and visualized using 0.05% DAB.
-
Immunofluorescence staining of Hela cell with CSB-RA561645A0HU at 1:50, counter-stained with DAPI. The cells were fixed in 4% formaldehyde, permeabilized using 0.2% Triton X-100 and blocked in 10% normal Goat Serum. The cells were then incubated with the antibody overnight at 4°C. The secondary antibody was Alexa Fluor 488-congugated AffiniPure Goat Anti-Rabbit IgG(H+L).
-
Overlay Peak curve showing Hela cells stained with CSB-RA561645A0HU (red line) at 1:100. The cells were fixed in 4% formaldehyde and permeated by 0.2% TritonX-100 for 10min. Then 10% normal goat serum to block non-specific protein-protein interactions followed by the antibody (1ug/1*106cells) for 45min at 4℃. The secondary antibody used was FITC-conjugated goat anti-rabbit IgG (H+L) at 1/200 dilution for 35min at 4℃.Control antibody (green line) was Rabbit IgG (1ug/1*106cells) used under the same conditions. Acquisition of >10,000 events was performed.
-
-
其他:
產(chǎn)品詳情
-
Uniprot No.:
-
基因名:SET
-
別名:2PP2A antibody; HLA DR associated protein II antibody; HLA-DR-associated protein II antibody; I 2PP2A antibody; I-2PP2A antibody; I2PP2A antibody; IGAAD antibody; Inhibitor of granzyme A activated DNase antibody; Inhibitor of granzyme A-activated DNase antibody; Inhibitor of GzmA-activated DNase antibody; inhibitor-2 of protein phosphatase-2A antibody; IPP2A2 antibody; PHAPII antibody; Phosphatase 2A inhibitor I2PP2A antibody; protein phosphatase type 2A inhibitor antibody; Protein SET antibody; Set antibody; SET nuclear oncogene antibody; SET translocation antibody; SET translocation (myeloid leukemia-associated) antibody; SET_HUMAN antibody; TAF I antibody; TAF IBETA antibody; TAF-I antibody; TAFI antibody; Template activating factor I antibody; Template-activating factor I antibody; Template-Activating Factor-I, chromatin remodelling factor antibody
-
反應(yīng)種屬:Human
-
免疫原:A synthesized peptide derived from human SET
-
免疫原種屬:Homo sapiens (Human)
-
標(biāo)記方式:Non-conjugated
-
克隆類型:Monoclonal
-
抗體亞型:Rabbit IgG
-
純化方式:Affinity-chromatography
-
克隆號(hào):5E6
-
濃度:It differs from different batches. Please contact us to confirm it.
-
保存緩沖液:Rabbit IgG in 10mM phosphate buffered saline , pH 7.4, 150mM sodium chloride, 0.05% BSA, 0.02% sodium azide and 50% glycerol.
-
產(chǎn)品提供形式:Liquid
-
應(yīng)用范圍:ELISA, WB, IHC, IF, FC
-
推薦稀釋比:
Application Recommended Dilution WB 1:500-1:2000 IHC 1:50-1:200 IF 1:50-1:200 FC 1:50-1:200 -
Protocols:
-
儲(chǔ)存條件:Upon receipt, store at -20°C or -80°C. Avoid repeated freeze.
-
貨期:Basically, we can dispatch the products out in 1-3 working days after receiving your orders. Delivery time maybe differs from different purchasing way or location, please kindly consult your local distributors for specific delivery time.
-
用途:For Research Use Only. Not for use in diagnostic or therapeutic procedures.
相關(guān)產(chǎn)品
靶點(diǎn)詳情
-
功能:Multitasking protein, involved in apoptosis, transcription, nucleosome assembly and histone chaperoning. Isoform 2 anti-apoptotic activity is mediated by inhibition of the GZMA-activated DNase, NME1. In the course of cytotoxic T-lymphocyte (CTL)-induced apoptosis, GZMA cleaves SET, disrupting its binding to NME1 and releasing NME1 inhibition. Isoform 1 and isoform 2 are potent inhibitors of protein phosphatase 2A. Isoform 1 and isoform 2 inhibit EP300/CREBBP and PCAF-mediated acetylation of histones (HAT) and nucleosomes, most probably by masking the accessibility of lysines of histones to the acetylases. The predominant target for inhibition is histone H4. HAT inhibition leads to silencing of HAT-dependent transcription and prevents active demethylation of DNA. Both isoforms stimulate DNA replication of the adenovirus genome complexed with viral core proteins; however, isoform 2 specific activity is higher.
-
基因功能參考文獻(xiàn):
- hsa_circ_0000673 promoted hepatocellular carcinoma malignant behaviors via regulating miR-767-3p/SET pathway. PMID: 29627570
- Findings indicate that TCE may induce hepatocyte apoptosis via SET-mediated dephosphorylation and overexpression of nucleolin. PMID: 28402964
- Recent studies showed that SET is overexpressed in breast cancers, ovary cancers and other malignancies. The strong correlation between SET expression levels and survival of ovarian cancer patients, and SET-mediated activation of androgen synthesis, strongly indicate a significant role in gynecologic cancers. Also, SET appears to exert its activity through PP2A-dependent as well as PP2A-independent mechanisms. [review] PMID: 28356029
- SET overexpression is associated with GC progression. PMID: 28677734
- The results demonstrate that NFkB plays an important role in regulation of the human SET gene expression. PMID: 27351675
- SET accumulation is implicated in epigenetic modifications, such as DNA hypomethylation and histone hypoacetylation. It is associated with gene expression regulation and chromatin organization, thereby affecting gene expression control, DNA damage repair, and genome instability. PMID: 28460463
- Data show that PP32 and SET/TAF-Ibeta proteins block HAT1-mediated H4 acetylation. PMID: 28977641
- SEToverexpression promotes morphological and oncogenic cell transformation of an oral keratinocyte cell. PMID: 28636114
- Overexpression of SET-Nup214 in HeLa cells leads to the formation of similar nuclear bodies that recruit CRM1, export cargo proteins, and certain nucleoporins and concomitantly affect nuclear protein and poly(A)(+) RNA export. PMID: 27613868
- Molecular chaperone SET-assisted eviction of linker histones and Shugoshins is a fundamental step in mammalian mitotic progression. PMID: 28781233
- Our findings suggested the oncogenic role of SET and the adverse prognostic value of SET overexpression in hepatocellular carcinoma (HCC). This alteration defines a subgroup of HCC patients who could benefit from SET antagonists, such as EMQA. PMID: 26876205
- This review summarizes and discusses the general mechanisms of H3K4 methylation, and how the six main enzymes from the SET/MLL family (responsible for H3K4me1/me2/me3) function in hematopoiesis and in hematologic malignancies. [review] PMID: 27796741
- identification of the oncoprotein SET as a major cellular factor whose binding with p53 is dependent on C-terminal domain acetylation status PMID: 27626385
- The findings of the present study suggested that the SET gene may contribute to tumorigenesis and may be a potential novel effective therapeutic target for leukemia and other cancer types. PMID: 27035430
- Data indicate that SET protein as a direct target of microRNA miR-125b, and the downregulation of SET, observed during tumor migration, was affected by the overexpression of miR125b. PMID: 27383536
- significance of SET/I2PP2A-mediated PP2A and non-PP2A pathways in polycystic ovary syndrome PMID: 27836688
- Both SET protein levels (and BACE1) were increased in Down syndrome patients. PMID: 24935721
- SET interacts with the Kruppel-associated box (KRAB)-associated co-repressor KAP1, and its overexpression results in the sustained retention of KAP1 and Heterochromatin protein 1 (HP1) on chromatin PMID: 25818296
- the results of the present study demonstrated that SET was associated with paclitaxel resistance in MCF-7/PTX cells, and that paeonol reversed paclitaxel resistance in MCF-7/PTX cells by downregulating the activity of the SET/PP2A/Akt pathway. PMID: 25760096
- These findings establish a framework for understanding the molecular basis of cytochrome c-mediated blocking of SET/TAF-Ibeta. PMID: 26216969
- Low SET expression is associated with bone metastasis in renal cell carcinoma. PMID: 26115722
- SET overexpression is a frequent event in metastatic colorectal cancer that plays a potential oncogenic role associated with worse outcome and resistance to oxaliplatin. PMID: 25388166
- A functional link between SET-mediated NDRG1 regulation. PMID: 25152373
- Therefore, SET overexpression in HEK293 cells promotes mitochondrial fission and reduces autophagic flux in apparent association with up-regulation of UCP2 and UCP3. PMID: 25656576
- The stable suppression of SET through RNA interference inhibited the growth, migration and invasion of breast cancer cells. Knockdown of SET increased the activity and expression of PP2Ac and decreased the expression of matrix metalloproteinase 9. PMID: 25234598
- Data indicate a therapeutic paradigm of inhibitor-2 of protein phosphatase-2A (SET) antagonism using OP449 in combination with tyrosine kinase inhibitors for the treatment of chronic myeloid leukemia (CML) and acute myeloid leukemia (AML) cell lines. PMID: 24436473
- Inactivation of nuclear localization signal causes retention of I2PP2A in the cell cytoplasm, where it promotes Tau hyperphosphorylation by affecting PP2A signaling. PMID: 25128526
- SET/TAF-Ibeta inhibits FoxO1 acetylation and activates its transcriptional activity toward p21 PMID: 24983498
- SET accumulation has important actions in head and neck squamous cell carcinoma PMID: 24555657
- SET/TAF-Ibeta interacts with Ku70/80 in the nucleus and inhibits Ku70 acetylation. PMID: 24305947
- SET is overexpressed in about 50-60% and CIP2A in about 90% of breast cancers. PMID: 24927563
- Set-beta differentially regulates axon growth and regeneration depending on subcellular localization and phosphorylation. PMID: 24849368
- C6-ceramide inhibits I2PP2A mediated upregulation of c-Myc and downregulation of histone acetylation in prostate cancer cells. PMID: 24025258
- When compared with SET-NUP214-negative patients, SET-NUP214-positive patients showed a significantly higher rate of corticosteroid resistance (91% vs 44%; P = .003) and chemotherapy resistance (100% vs 44%; P = .0001). PMID: 24449214
- Data show that SET accumulation up-regulated hnRNPK mRNA and total/phosphorylated protein, promoted hnRNPK nuclear location, and reduced Bcl-x mRNA levels. PMID: 24508256
- Detention of cytoplasmic SET protein occurs with Ser9 phosphorylation in Alzheimer's disease. PMID: 23374587
- TAF-Ibeta promotes BZLF1 expression and subsequent lytic infection by affecting chromatin at the BZLF1 promoter PMID: 23691099
- Recombinant SET with phosphorylation-mimic Ser171 to Glu substitution reduced its inhibitory effects on PP2A phosphatase activity compared with Ser171 to Ala substituted or wild-type SET PMID: 23251465
- SET is potential marker for head and neck squamous cell carcinoma associated with cancer cell resistance PMID: 22739068
- SET protein interacts with intracellular domains of the gonadotropin-releasing hormone receptor and differentially regulates receptor signaling to cAMP and calcium in gonadotrope cells PMID: 23233674
- A SET mutant, lacking a nuclear localization signal, SET(DeltaNLS), promotes cell spreading and motility. This was accompanied by an increase in the number and frequency of membrane ruffles. PMID: 23195690
- SET downregulated repair genes ATM, BRCA1 and CHEK2 and upregulated TP53 PMID: 23106910
- SET/TAF-Ibeta is sequentially recruited to the target gene promoter ATF3 after the PRC2 complex via H3K27me recognition and may offer additive effects in the repression of the target gene. PMID: 22796192
- SET knockdown increased high-affinity binding of agonist in intact cells and membrane preparations. PMID: 22466417
- Results showed that SET is significantly overexpressed in pediatric acute lymphoblastic leukemia samples, and an increased level of SET might contribute to leukemic process. PMID: 22677993
- SET overexpression is a key mechanism in the inhibition of PP2A in acute myeloid leukemia. PMID: 22133779
- Suggest that accumulated SET could act via Akt/PTEN either as cell survival signal or as oxidative stress sensor for cell death. PMID: 22143534
- Data describe the relatively high incidence of SET-NUP214 rearrangement in adult T-ALLs, and demonstrate comprehensive clinical, phenotypic, and genetic characteristics of this entity. PMID: 21720744
- crystals of template-activating factor Ibeta diffracted to 2.7 A resolution and belonged to space group P4(3)2(1)2. PMID: 20693670
- TAF-I is a key molecule that regulates linker histone-mediated chromatin assembly and disassembly PMID: 21940793
顯示更多
收起更多
-
相關(guān)疾病:A chromosomal aberration involving SET is found in some cases of acute undifferentiated leukemia (AUL). Translocation t(6;9)(q21;q34.1) with NUP214/CAN.
-
亞細(xì)胞定位:Cytoplasm, cytosol. Endoplasmic reticulum. Nucleus, nucleoplasm. Note=In the cytoplasm, found both in the cytosol and associated with the endoplasmic reticulum. The SET complex is associated with the endoplasmic reticulum. Following CTL attack and cleavage by GZMA, moves rapidly to the nucleus, where it is found in the nucleoplasm, avoiding the nucleolus. Similar translocation to the nucleus is also observed for lymphocyte-activated killer cells after the addition of calcium.
-
蛋白家族:Nucleosome assembly protein (NAP) family
-
組織特異性:Widely expressed. Low levels in quiescent cells during serum starvation, contact inhibition or differentiation. Highly expressed in Wilms' tumor.
-
數(shù)據(jù)庫(kù)鏈接:
Most popular with customers
-
-
YWHAB Recombinant Monoclonal Antibody
Applications: ELISA, WB, IHC, IF, FC
Species Reactivity: Human, Mouse, Rat
-
Phospho-YAP1 (S127) Recombinant Monoclonal Antibody
Applications: ELISA, WB, IHC
Species Reactivity: Human
-
-
-
-
-